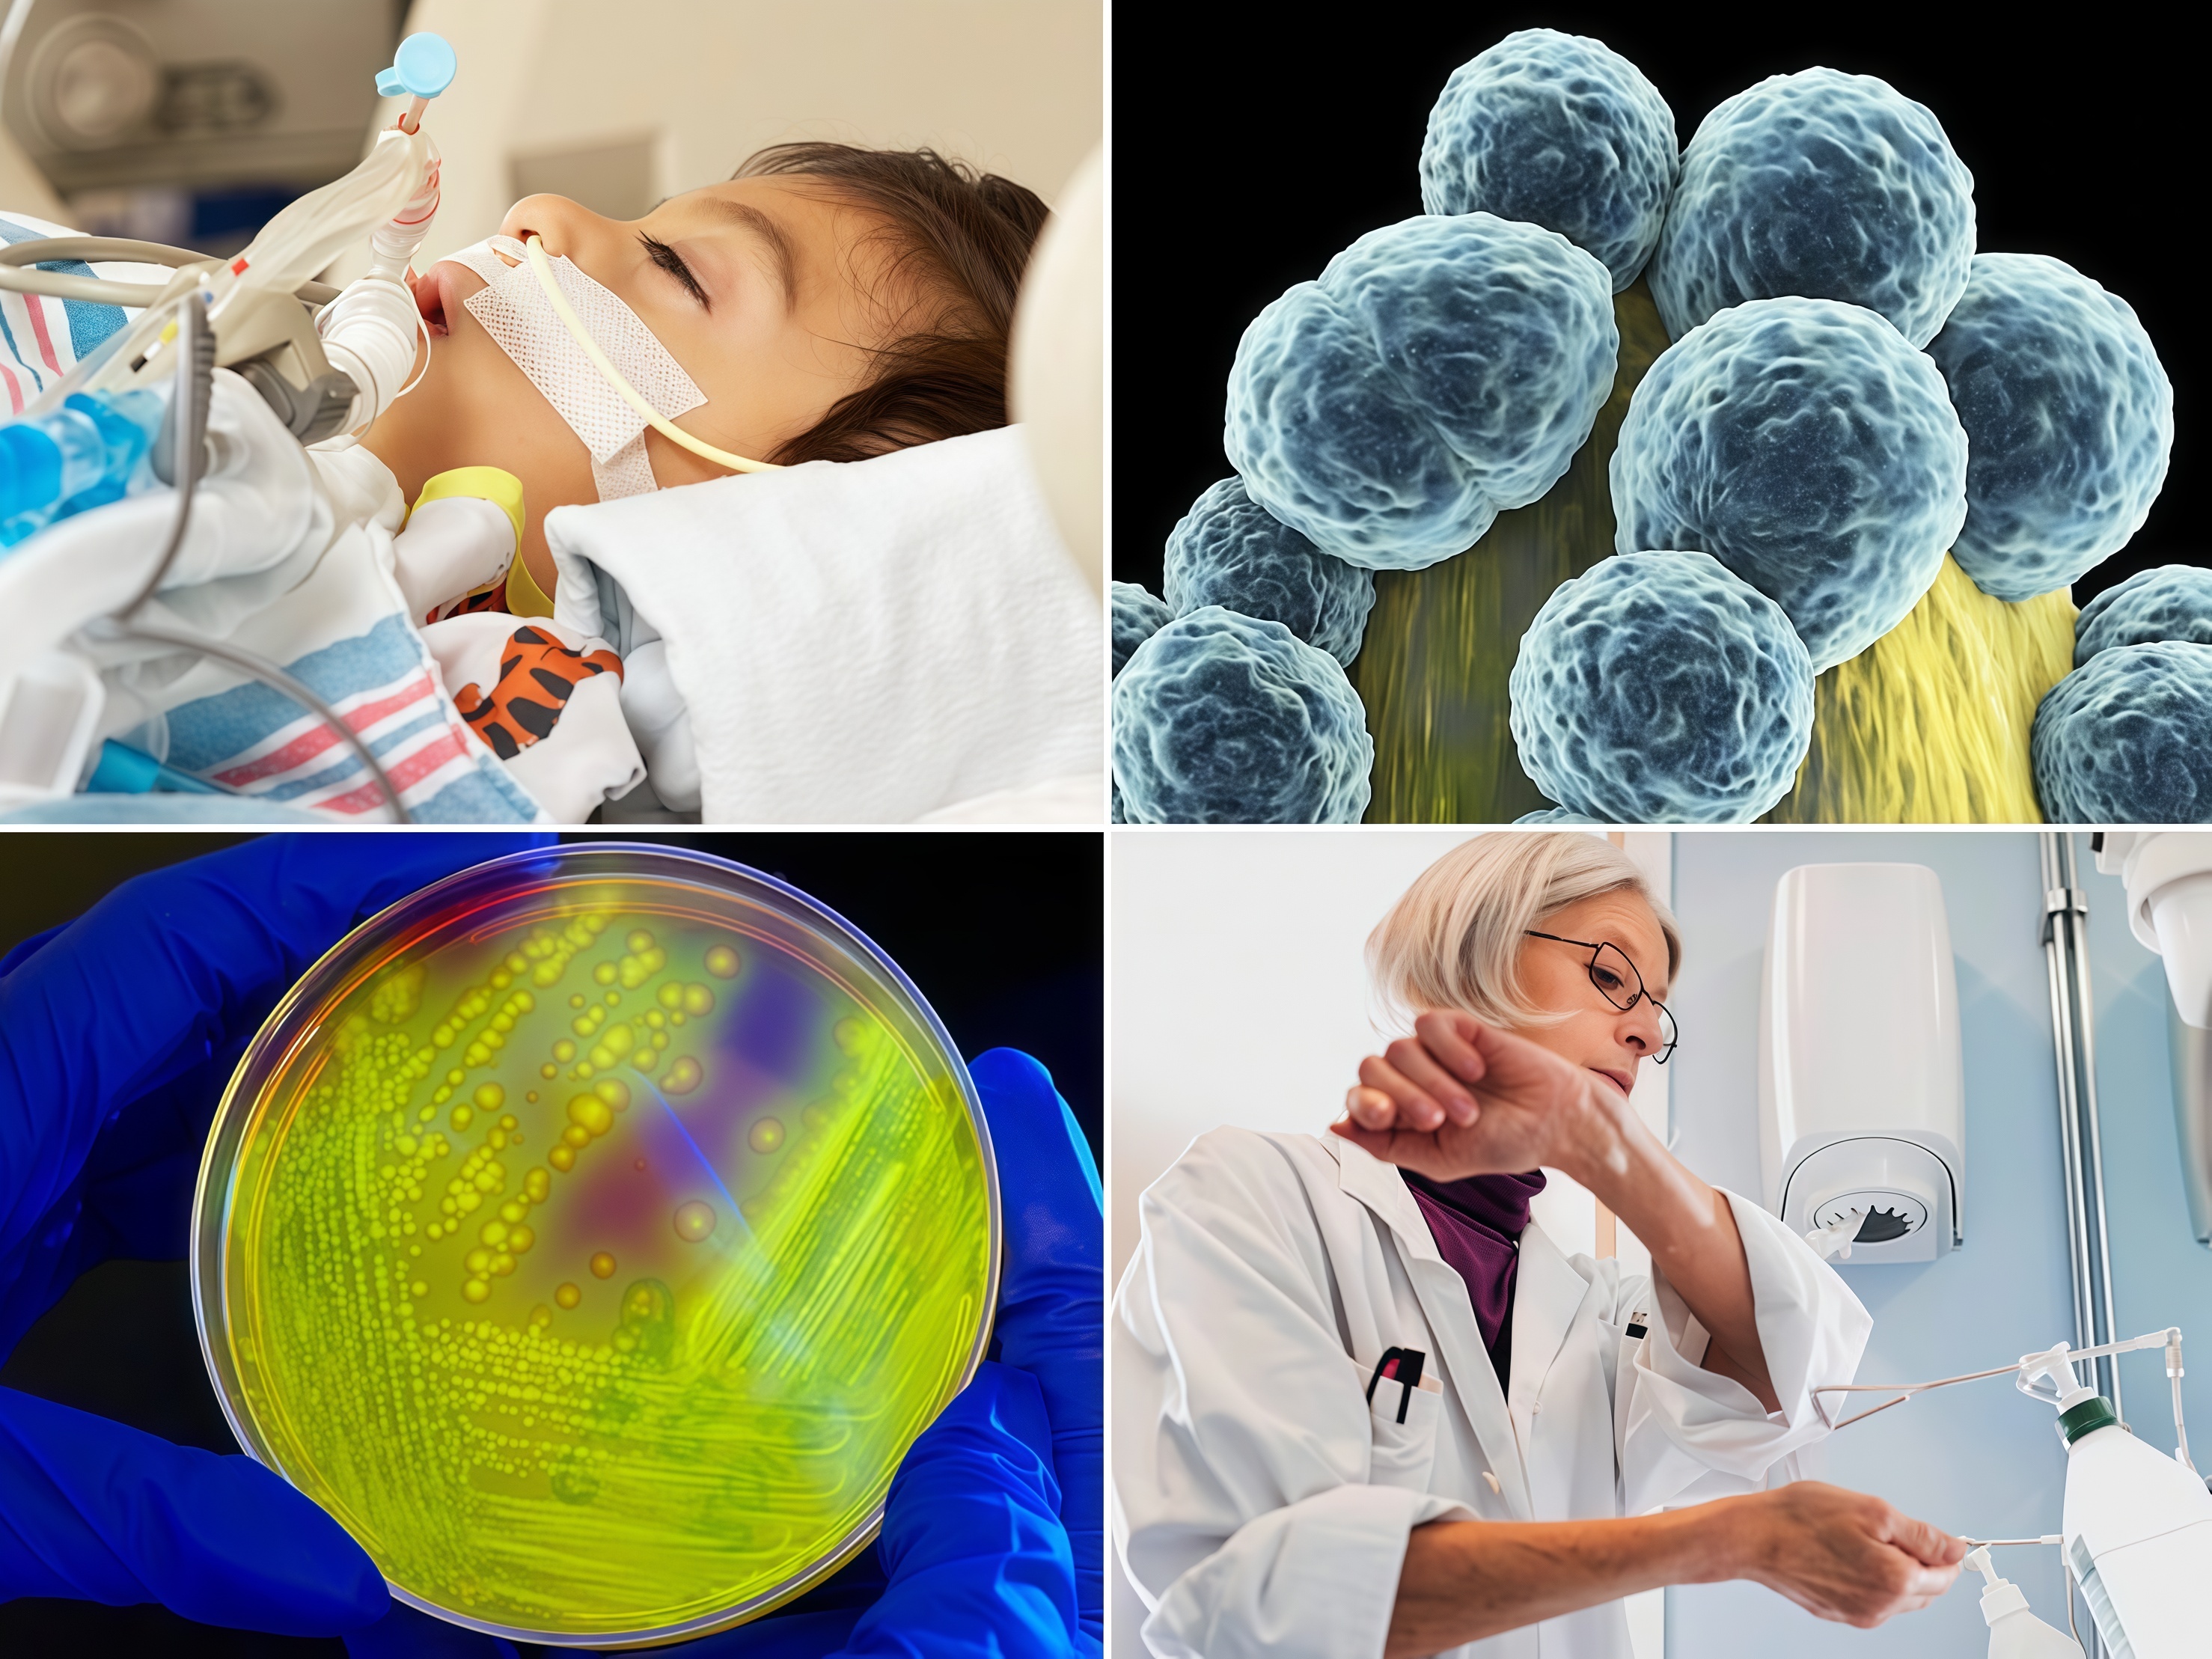
infection risk infection risk

Views: 0 Author: Site Editor Publish Time: 2026-01-14 Origin: Site
Healthcare-associated infections (HAIs) represent one of the most persistent challenges facing modern medical facilities. According to the World Health Organization, between 7% and 15% of hospitalized patients acquire at least one HAI during their hospital stay, with fatal outcomes occurring in approximately 10% of affected cases. Yet this alarming statistic often obscures a critical and preventable factor: the role of environmental surfaces—particularly healthcare furniture—in pathogen transmission.
Recent epidemiological research has established unequivocally that contaminated surfaces and healthcare worker hand contact account for the majority of cross-transmission events within clinical environments. A comprehensive 2025 study published in Frontiers in Public Health documented significant positive correlations between high-touch surface (HTS) contamination and HAI incidence rates, with environmental colony counts demonstrating lag effects of up to three months before manifesting in patient infection patterns. This finding carries profound implications for facility administrators: the furniture materials selected today directly determine infection risk profiles for months to come.
This guide explores how healthcare facility administrators and procurement teams can leverage scientific evidence on material properties, disinfection protocols, and regulatory compliance frameworks to make informed furniture selections that meaningfully reduce HAI transmission risk while maintaining resident comfort and operational efficiency.
The contribution of environmental factors to HAI transmission is far more significant than many healthcare administrators realize. While direct patient-to-patient transmission captures public attention, research consistently demonstrates that contaminated surfaces serve as critical pathogen reservoirs within clinical environments.

A landmark 2025 observational study tracking environmental hygiene metrics across hospital facilities documented 7,455 HAIs over a 30-month period, yielding a cumulative incidence rate of 1.56% with monthly averages of 248.5 cases. The analysis revealed that facilities with superior high-touch surface (HTS) contamination control measures demonstrated significantly lower HAI incidence rates compared to facilities with standard cleaning protocols: 1.26% versus 1.59% (p < 0.001). The practical significance of this 0.33 percentage point difference translates into 40-60 fewer HAI cases annually in a 500-bed facility.
Cross-contamination by healthcare workers—who contact contaminated surfaces and then touch patients or other surfaces—accounts for an estimated 30-40% of all HAIs. Research examining noncritical medical items in clinical settings documented contamination in 23-100% of tested surfaces, with pathogenic organisms present in 80% of contaminated items and multidrug-resistant organisms (MDROs) detected in up to 25% of samples.
The implication is stark: infection control strategies relying exclusively on hand hygiene and disinfection protocols without attention to surface material properties remain fundamentally incomplete. Healthcare facility furniture—seating in waiting rooms, patient chairs, clinical workstations, common areas—represents high-touch surfaces where pathogenic organisms establish persistent reservoirs.
The financial consequences of HAI transmission extend far beyond direct treatment costs. A single healthcare-associated infection increases patient hospitalization by an average of 10-15 additional days, with direct attributable costs ranging from $15,000 to $45,000 per patient depending on infection severity and complication profile. For a 300-bed facility with baseline HAI incidence of 1.5%, inadequate infection prevention through material selection translates into 4-5 additional patients acquiring infections annually—a financial burden of $60,000-$225,000 in direct incremental costs.
Beyond monetary considerations, HAIs damage institutional reputation, reduce patient and family confidence, and trigger regulatory scrutiny. State health departments increasingly track and publicly report Standard Infection Rates (SIR), creating transparency that directly influences community perception, referral patterns, and patient admissions. A facility demonstrating below-average SIR scores gains competitive advantage in patient choice and payer negotiations; conversely, above-average infection rates trigger quality improvement mandates and potential reimbursement penalties.
Material selection in healthcare furniture represents a strategic lever for HAI prevention. While furniture constitutes a capital investment, the infection prevention return on investment significantly exceeds initial cost considerations.

Traditional fabric upholstery—constructed from woven textile fibers—presents fundamental pathogen control challenges that stem from material physics rather than cleaning protocols.
Fabric's porous structure creates microscopic spaces between fibers that serve as ideal pathogen reservoirs. Bacteria, viruses, and fungal organisms colonizing these spaces are shielded from disinfectant contact by the tortuous geometry of the textile structure. A 2008 comparative study examining cloth-covered treatment surfaces documented discovery of numerous microbacterial strains including Staphylococcus aureus and Propionibacterium, along with allergen-producing molds including Candida. Critically, the study documented that cloth surfaces—despite routine cleaning protocols—harbored both pathogens and allergens at levels far exceeding those found on vinyl-covered comparison surfaces.
The infection control failure of fabric extends beyond initial contamination to persistence. Research on vancomycin-resistant Enterococci (VRE) transmission demonstrated that while disinfectant treatment significantly reduced bacterial colony counts on vinyl surfaces within hours, fabric surfaces retained viable VRE at measurable levels for extended periods due to fibrous entrapment protecting organisms from chemical exposure.
Moisture absorption represents a secondary failure mechanism. Fabric's hygroscopic nature—its tendency to absorb moisture—creates an ideal environment for microbial proliferation. Bodily fluids, cleaning solutions, and environmental moisture penetrating fabric surfaces provide nutrients and hydration supporting bacterial and fungal growth. A contaminated fabric surface thus becomes progressively worse over time despite routine cleaning: initial infection does not clear, and resident moisture promotes exponential pathogen replication.
From a liability perspective, major healthcare purchasing consortiums and infection prevention guidelines have increasingly moved toward explicit recommendations against fabric upholstery in clinical environments, precisely because scientific evidence no longer supports its use from an infection control standpoint.
Vinyl upholstery, constructed from polyvinyl chloride (PVC) compounds, provides fundamentally different infection control properties compared to fabric. Vinyl's nonporous, impermeable surface creates an absolute barrier between environmental pathogens and the furniture's interior cushioning.
The physics of vinyl's protective mechanism operates through two complementary principles:
Surface impermeability: Vinyl's nonporous structure eliminates the microscopic spaces that enable pathogen entrapment. Bacteria encountering a vinyl surface cannot penetrate or embed within the material; they remain on the exposed surface where disinfectants can make direct contact and achieve microbicidal activity.
Moisture resistance: Vinyl's hydrophobic properties prevent absorption of bodily fluids, cleaning solutions, and environmental moisture. This characteristic eliminates the aqueous environment that pathogens require for proliferation. A vinyl surface, unlike fabric, becomes progressively cleaner rather than progressively more contaminated over extended periods between cleaning cycles.
Laboratory testing conducted by the Coated Fabric and Fabric Association (CFFA) and major material science organizations validates vinyl's superior performance. When comparing vinyl-coated upholstery materials exposed to 23 leading hospital-grade disinfectants under accelerated testing protocols designed to simulate months of clinical use, vinyl materials demonstrated exceptional resistance to both disinfectant degradation and bacterial colonization. Visual examination post-disinfection revealed minimal color change and structural integrity preservation across all vinyl specimens tested.
A particularly striking comparative study on VRE (vancomycin-resistant Enterococci) transmission found that smooth vinyl surfaces achieved substantially lower pathogen recovery rates compared to other materials tested—contradicting conventional assumptions that smooth surfaces would be more likely to transmit infection. The explanation lies in surface impermeability: vinyl's nonporous character combined with its resistance to disinfectant interaction created optimal conditions for pathogen removal rather than persistence.
For healthcare facility procurement teams, vinyl upholstery represents the material science consensus choice for infection control applications. The question is not whether to select vinyl, but which vinyl formulation and antimicrobial enhancement strategy best serves the facility's specific infection prevention objectives.

While vinyl's nonporous structure provides the foundational barrier protecting facilities from pathogen transmission, antimicrobial fabric treatments represent the premium tier of infection control enhancement—delivering additional layers of pathogenic organism suppression beyond material properties alone.
Crypton performance fabric has emerged as the market-leading specification for healthcare environments, with approximately 90% of commercial and healthcare design professionals choosing Crypton-coated materials for infection-critical applications. Crypton's technology platform integrates two complementary antimicrobial mechanisms: silver ion technology providing broad-spectrum microorganism suppression, and integrated moisture barriers preventing pathogen proliferation.
The silver ion antimicrobial mechanism operates through ionic disruption of bacterial cell membranes and enzymatic deactivation. This mechanism—derived from centuries-old knowledge of silver's germicidal properties—provides efficacy against an exceptionally broad pathogen spectrum:
| Pathogenic Target | Efficacy | Clinical Significance |
MRSA (Methicillin-resistant Staphylococcus aureus) | 99.9% kill rate | Most problematic HAI pathogen in US facilities |
VRE (Vancomycin-resistant Enterococci) | 99.9% kill rate | Increasingly prevalent antibiotic-resistant organism |
E. coli | 99.9% kill rate | Common environmental contamination vector |
H1N1 influenza | Effective | Seasonal pandemic risk management |
SARS-CoV-2 (COVID-19) | Effective | Ongoing pandemic threat |
Mold and mildew | Complete inhibition | Moisture-related contamination prevention |
Crypton fabric carries EPA certification as disinfectable when used in conjunction with Crypton Disinfectant & Deodorizer, a quaternary ammonium compound specifically formulated for compatibility with Crypton's integrated barrier coating. The three-year testing and EPA approval process required Crypton to establish new protocol test procedures, reflecting the rigor of validation supporting its antimicrobial claims.
Critically, Crypton achieves antimicrobial efficacy without incorporating PFAS (perfluoroalkyl substances), formaldehyde, or volatile organic compounds (VOCs)—chemicals increasingly restricted in healthcare facility specifications due to environmental and occupational health concerns. This profile positions Crypton as both an infection control solution and an environmentally responsible specification choice.
Dartex performance fabric represents an alternative antimicrobial platform offering similar infection control benefits through different chemical mechanisms. While less widely deployed than Crypton in North American healthcare markets, Dartex fabrics demonstrate equivalent or superior performance in accelerated laboratory disinfection testing protocols and offer cost advantages in certain healthcare segment applications.
The selection between Crypton and Dartex typically depends on facility-specific requirements around warranty duration, disinfectant compatibility, budget constraints, and aesthetic preferences. Both materials deliver substantial infection prevention benefits compared to standard vinyl or fabric alternatives.
Healthcare facility furniture selection operates within a regulatory framework that has evolved substantially over the past decade, with infection control now explicitly incorporated into facility design and equipment standards across most developed healthcare systems.
In the United Kingdom, the Department of Health and Social Care establishes explicit guidance on soft furnishings in patient areas, requiring that all upholstered surfaces be selected from materials meeting defined infection control performance standards. These guidelines specifically mandate:
Nonporous surface requirements: All upholstered surfaces must resist liquid penetration and pathogen absorption
Disinfectant compatibility: Furnishings must remain structurally and chemically intact following exposure to standard hospital-grade disinfectants (quaternary ammonium compounds, phenolic agents, oxidative disinfectants)
Cleanability standards: Surfaces must achieve documented pathogen reduction of at least 99% following standard disinfection protocols
Maintenance criteria: Furnishings must maintain performance characteristics through expected service life under typical hospital cleaning conditions
The regulatory emphasis reflects epidemiological evidence demonstrating that furniture material selection directly influences HAI transmission rates within facilities. Regulatory bodies have moved from discretionary recommendations toward mandatory compliance requirements precisely because scientific evidence validates that material choices measurably improve patient safety outcomes.
Contemporary infection control risk assessment frameworks integrate furniture material selection as a critical environmental control point. The process typically follows a structured format:
1. Hazard identification: Document all furniture items serving high-touch functions (patient chairs, caregiver seating, common area furnishings, clinical workstations)
2. Transmission risk assessment: Evaluate pathogen transmission likelihood based on furniture function, patient population served, and material properties
3. Current control effectiveness evaluation: Assess efficacy of existing materials and cleaning protocols in reducing transmission risk
4. Gap analysis: Identify where material properties or cleaning procedures fall below infection control standards
5. Remediation prioritization: Sequence furniture replacement decisions based on transmission risk magnitude and replacement cost efficiency
6. Control validation: Monitor pathogenic organism recovery from treated surfaces post-remediation to validate infection risk reduction
Healthcare facilities implementing structured risk assessment frameworks typically discover that 40-60% of existing furniture fails to meet modern infection control standards and represents priority replacement candidates. The assessment process, while requiring administrative resources, generates quantifiable data justifying capital expenditure for infection control-focused furniture upgrades.

Effective disinfection of healthcare furniture begins with standardized daily cleaning procedures that facility staff consistently execute. The process follows a defined protocol designed to maximize pathogen elimination while minimizing material damage risk:
Step 1 - Pre-disinfection surface preparation (5-10 minutes per surface)
Remove visible contamination (blood, bodily fluids, organic debris) using absorbent materials
Pre-rinse with water or enzymatic cleaners if heavy soiling present
Allow enzymatic cleaner contact time per manufacturer instructions (typically 5-10 minutes)
Wipe clean with lint-free cloth or disposable wipes
Step 2 - Disinfectant application (5 minutes)
Select hospital-approved disinfectant compatible with vinyl surface type (quaternary ammonium, phenolic, or hypochlorite-based agents acceptable for most vinyl formulations)
Apply disinfectant using spray application or saturated cloth method
Ensure complete surface coverage
Allow contact time per disinfectant product instructions (typically 30 seconds to 10 minutes depending on product formulation and target pathogens)
Step 3 - Removal and drying (3-5 minutes)
Wipe disinfectant residue thoroughly with clean cloth
Dry surface completely to prevent moisture accumulation
Allow air drying if residual moisture remains
Expected frequency: For high-touch furniture in acute care settings, daily disinfection following the procedure above represents the minimum standard. Intensive-use areas (emergency departments, intensive care units) may require two or more daily cycles. Routine observation should guide frequency adjustment based on usage patterns and visible soiling.
While vinyl's nonporous nature provides inherent protection against pathogen penetration, disinfectant chemical compatibility remains critical to furniture longevity and material integrity. Not all hospital-grade disinfectants are compatible with all vinyl formulations—a reality that facility procurement teams must address during furniture specification.
Research examining vinyl upholstery exposure to 23 leading hospital-approved disinfectants revealed significant variation in material compatibility. Advanced accelerated testing protocols exposed vinyl samples to multiple disinfection cycles simulating months of clinical use, then measured visual color change and structural integrity degradation using objective colorimetric analysis.
Compatible disinfectants (minimal material degradation):
Quaternary ammonium compounds (QACs): Highly compatible; widely used in healthcare facilities; effective against broad pathogen spectrum including MRSA and VRE
Phenolic disinfectants: Generally compatible with most vinyl formulations; longer contact times typically required
Hydrogen peroxide-based disinfectants: Compatible when used per manufacturer dilution and contact time specifications
Conditionally compatible disinfectants (material degradation at higher concentrations or extended contact times):
Hypochlorite (bleach) solutions: Compatible at dilutions ≤500 ppm; concentrations exceeding this threshold can cause color fading and material brittleness with repeated exposure
Aldehyde-based agents: Compatible if rinsed thoroughly post-disinfection to prevent residual chemical damage
Incompatible or contraindicated disinfectants:
Strong acidic or alkaline agents: Can cause surface etching and degradation
Solvent-based disinfectants: May cause vinyl softening or material compromise
Undiluted concentrated disinfectants: Risk of irreversible material damage
Facility-specific compatibility validation represents a critical procurement step. Before facility-wide disinfection protocol adoption, healthcare facilities should conduct small-scale compatibility testing on actual furniture samples using facility-approved disinfectants under anticipated use conditions. This preventive measure eliminates the risk of inadvertently damaging $50,000-$200,000 furniture investments through incompatible chemical selection.
Despite optimal care and compatible disinfection protocols, healthcare furniture eventually reaches end-of-service life and requires replacement. Establishing clear replacement criteria ensures that deteriorated furnishings don't become infection control liabilities or patient safety hazards.
Structural integrity failure indicators (replacement recommended):
Tears, punctures, or seams separating: Even small openings expose internal cushioning to pathogen colonization and moisture infiltration
Loss of structural support: Cushioning degradation reducing functionality and creating fall risk
Loose fasteners or frame components: Safety hazard for mobility-impaired patients
Irreparable stains or discoloration: Aesthetic concerns affecting resident perception of facility cleanliness
Functional obsolescence indicators (replacement considered):
Incompatibility with current facility disinfection protocols: Older furniture formulations may not withstand modern disinfectant chemistries
Inability to meet updated regulatory standards: Facilities refreshing infection control protocols may require upgraded furniture meeting new specifications
Limited warranty remaining: Once furniture warranty expires, repair costs escalate substantially
Economic replacement criteria:
Furniture age exceeding 80% of expected service life: Repair costs typically approach 40-60% of replacement cost for items in this age range
Cumulative maintenance costs exceeding 20% of original purchase price annually: Economic indicator that replacement is more cost-effective than ongoing repair
A typical healthcare facility should anticipate furniture replacement cycles of 12-15 years for premium vinyl upholstery (Crypton or equivalent antimicrobial specification) and 8-10 years for standard vinyl with minimal antimicrobial treatment. Quality manufacturers like Hongye Healthcare Furniture—with its 86+ product certifications and 5,000-person technical staff—design furniture specifically for extended service life under intensive healthcare use conditions, consistently achieving or exceeding these replacement timelines.

Healthcare facility procurement teams tasked with furniture selection face complex decisions balancing infection control efficacy, budget constraints, aesthetic requirements, and vendor relationships. A systematic procurement approach addresses these competing demands:
Specification development:
Define infection control requirements based on facility risk assessment and regulatory obligations
Identify disinfection protocols facility staff will employ (quaternary ammonium, bleach, phenolic agents)
Specify antimicrobial enhancement requirements (standard vinyl, Crypton-equivalent, or premium formulations)
Document comfort and aesthetic requirements
Establish expected service life and warranty requirements
Vendor evaluation:
Request third-party laboratory testing documentation demonstrating disinfectant compatibility and antimicrobial efficacy
Verify manufacturer certifications (ISO standards, health care product approvals)
Assess financial stability and warranty fulfillment track record
Request facility-specific design consultation and customization capabilities
Total cost of ownership analysis:
| Cost Category | Standard Vinyl | Crypton/Premium Vinyl |
Initial purchase cost (per unit) | $800-1,200 | $1,400-2,000 |
Expected service life (years) | 8-10 | 12-15 |
Annual replacement rate (%) | 10-12% | 6-8% |
Annual replacement cost per unit | $80-144 | $112-160 |
Annual maintenance/repair (estimated) | $120-180 | $60-90 |
Disinfectant compatibility issues (cost/frequency) | Occasional | Rare |
5-year cost per unit | $2,400-3,420 | $2,960-3,600 |
10-year cost per unit | $4,800-6,840 | $4,720-6,400 |
The analysis reveals that premium vinyl formulations (Crypton or equivalent) achieve cost parity with standard vinyl by year 5, then demonstrate clear cost superiority by years 8-10 due to extended service life and reduced maintenance requirements. For 100-unit facilities, the 10-year cost difference between standard and premium vinyl approaches $8,000-$24,000—a substantial economic advantage favoring premium specifications from a purely financial perspective, independent of superior infection control benefits.
Hongye Healthcare Furniture Integration: Manufacturers like Guangdong Hongye Furniture Manufacturing Co., Ltd—with 16 years of healthcare furniture specialization, 5,000 technical staff, and partnerships across 300+ healthcare facilities globally—provide procurement advantages extending beyond product availability. Hongye's design expertise in infection control furniture specifications, combined with manufacturing capacity supporting facility-wide standardization initiatives, creates operational efficiencies that smaller or less specialized manufacturers cannot provide. Facilities standardizing on Hongye materials benefit from consistent material properties across all furniture items, simplified maintenance protocol development, and streamlined vendor relationships.
Saudi German Hospital Makkah | Medical Project Solution By Hongye Furniture
Q: Is Crypton fabric worth the premium cost compared to standard vinyl?
A: Crypton's 12-15 year service life compared to standard vinyl's 8-10 years, combined with reduced maintenance requirements, achieves cost parity by year 8-10 and demonstrates clear economic advantage thereafter. From a pure infection control standpoint, Crypton's EPA-certified disinfectability and silver ion antimicrobial mechanism provide enhanced safety margins relative to standard materials. For most healthcare facilities viewing furniture as a 10+ year capital investment, Crypton represents the economically and clinically optimal choice.
Q: Can we use fabric upholstery in healthcare if we clean it more frequently?
A: No. Increased cleaning frequency does not overcome fabric's fundamental material limitations regarding pathogen penetration and retention. Bacteria and viruses embeded within fabric fibers remain inaccessible to disinfectant contact regardless of cleaning frequency. Clinical evidence and regulatory guidance consistently recommend against fabric upholstery in any healthcare patient-care environment, regardless of cleaning protocols.
Q: What disinfectant should we use on our healthcare furniture?
A: Select quaternary ammonium compound (QAC) disinfectants as the primary choice for most healthcare vinyl upholstery. QACs offer broad-spectrum efficacy against MRSA, VRE, and respiratory pathogens; compatibility with vinyl surfaces; and operational convenience. Consult your furniture manufacturer's specification to confirm compatibility with your specific upholstery formulation before facility-wide adoption.
Healthcare facility administrators and procurement teams operate within an environment of increasingly constrained budgets, rising infection control accountability, and growing patient/family expectations for safety. Infection control through healthcare furniture selection represents a strategic opportunity to simultaneously improve patient safety outcomes, reduce operational costs, and demonstrate institutional commitment to evidence-based infection prevention.
The scientific evidence is unambiguous: vinyl upholstery with antimicrobial enhancement (Crypton or equivalent) eliminates approximately 99% of the pathogen persistence risk inherent to fabric alternatives. Implementation of systematic disinfection protocols and staff training completes the infection prevention strategy, creating measurable reductions in healthcare-associated infections.
The financial case is equally compelling: premium vinyl formulations achieve cost parity with standard materials within 8-10 years while delivering extended service life, reduced maintenance requirements, and superior infection control outcomes. For facilities viewing healthcare furniture as a strategic patient safety and operational efficiency investment, the return on investment extends far beyond simple cost-per-unit calculations.
Healthcare facilities committed to evidence-based infection prevention practices should prioritize comprehensive assessment of existing furniture, systematic replacement of materials failing current standards, and standardization on vinyl upholstery formulations meeting modern antimicrobial specifications. Manufacturers like Hongye Healthcare Furniture, with deep specialization in healthcare environments and technical capacity supporting facility-wide implementation, provide procurement partners capable of delivering both material excellence and operational support.
The path forward is clear: implement evidence-based material selection today to measurably reduce infection risk, improve patient outcomes, and optimize long-term capital efficiency. Patient safety and operational excellence converge in systematic attention to the materials surrounding vulnerable patient populations.